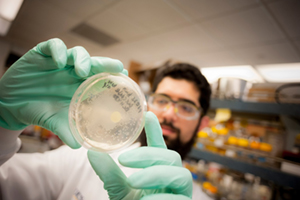
Man looking at sample

Students

Resources for Students
Learn more about applying to UC San Diego’s graduate specialization in Immunology. Admissions deadlines and requirements vary by parent program, so please check the specific program you are interested in for further information.
Current and Prospective Students can learn more about student life at UC San Diego. Find access to student resources on campus including, Student Health Services, Career Services, Campus Maps, and more.
In addition to the fellowships and grants provided by UCSD, students and faculty part of the Immunology program have access to some of the best research services and facilities to support their work including the LJI Core Facilities, the UCSD Institute for Genomic Medicine, as well as shared resources provided by Moores Cancer Center.
Learn more about the Program’s BioLegend Fellowship Program, awarded to Program members at the La Jolla Institute and UC San Diego.